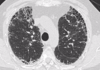

calcificaciones mediastinicas en Cascara huevo?

Silicosis
Algoritmo espirometria

Volumenes espirometria

Volumenes espirometria

Primer parámetro que se altera en fumador
F. mesoespiratória : 75-25%
> 60%
Enfermedades restrictivas

Causas más frecuentes disminución DLCO ( < 80 % )
Aumento mb alveolocapilar:
- Alteración mb alv : ENFISEMA
- Grosor intersticio : EPID
- Endotelio: anemia, TEP, ICC
Causas aumento DLCO ( > 120 %)
Poliglobulia
Hemorragia alveolar
Asma
Embarazo
Fórmulas gradiente alveolo-capilar
D(A-a) O2= PAO2 - PaO2 <15
D(A-a) O2= 150 - ( PaCO2 x 1,25 ) - PaO2
Efecto BOHR
Disminución afinidad o2 en presencia CO2 + H+ ( capilares tisulares ) –> desplaza a derecha curva
Liberación o2 a tejidos
Factores desplazan curva hb a derecha
Acidosis
Aumento temperatura
Aumento 2-3 difosf
Aumento PaCO2
Hb fetal
Algoritmo hipoxemia

Dx intoxicación CO
CO-Oximetria
tto intoxicación cianuro
Hidroxicobalamina iv
Si tenemos O2 suplementario como vemos pO2
PaFiO2: Pao2/Fio2
> 400: normal
300-400: hipoxemia
< 300: IR
< 200: IR greu
¿ Cuándo encontramos percusión timpánica?
Enfisema
Neumotórax
Crisis Asmáticas
Qué auscultación encontramos en asma
Hiperinsuflación:
Percusión timpánica
Silencio auscultatorio ( grave )
Alargamiento espiratorio ( obstrucción flujo )
sibilancias
¿ Cuándo encontramos vibraciones disminuidas?
Derrame pleural
Neumotórax
¿ Cuándo encontramos vibraciones aumentadas?
Condensación pulmonar
¿ Cuándo encontramos crepitantes último 1/3 inspiración ( finos )?
Afectación parénquima pulmonar
¿ Cuándo encontramos crepitantes 1/3 inicial inspiración?
Exsudado bronquios grandes
¿ Cuándo encontramos soplo anfórico?
Cavernas TBC grandes, Neumotórax
Qué se presenta con un empeoramiento de su capacidad vital en decúbito supino
Enf. neuromuscular
Paciente con tos i disnea que presenta edema en esclavina

Sd vena cava superior ( Ca microcítico pulmón )